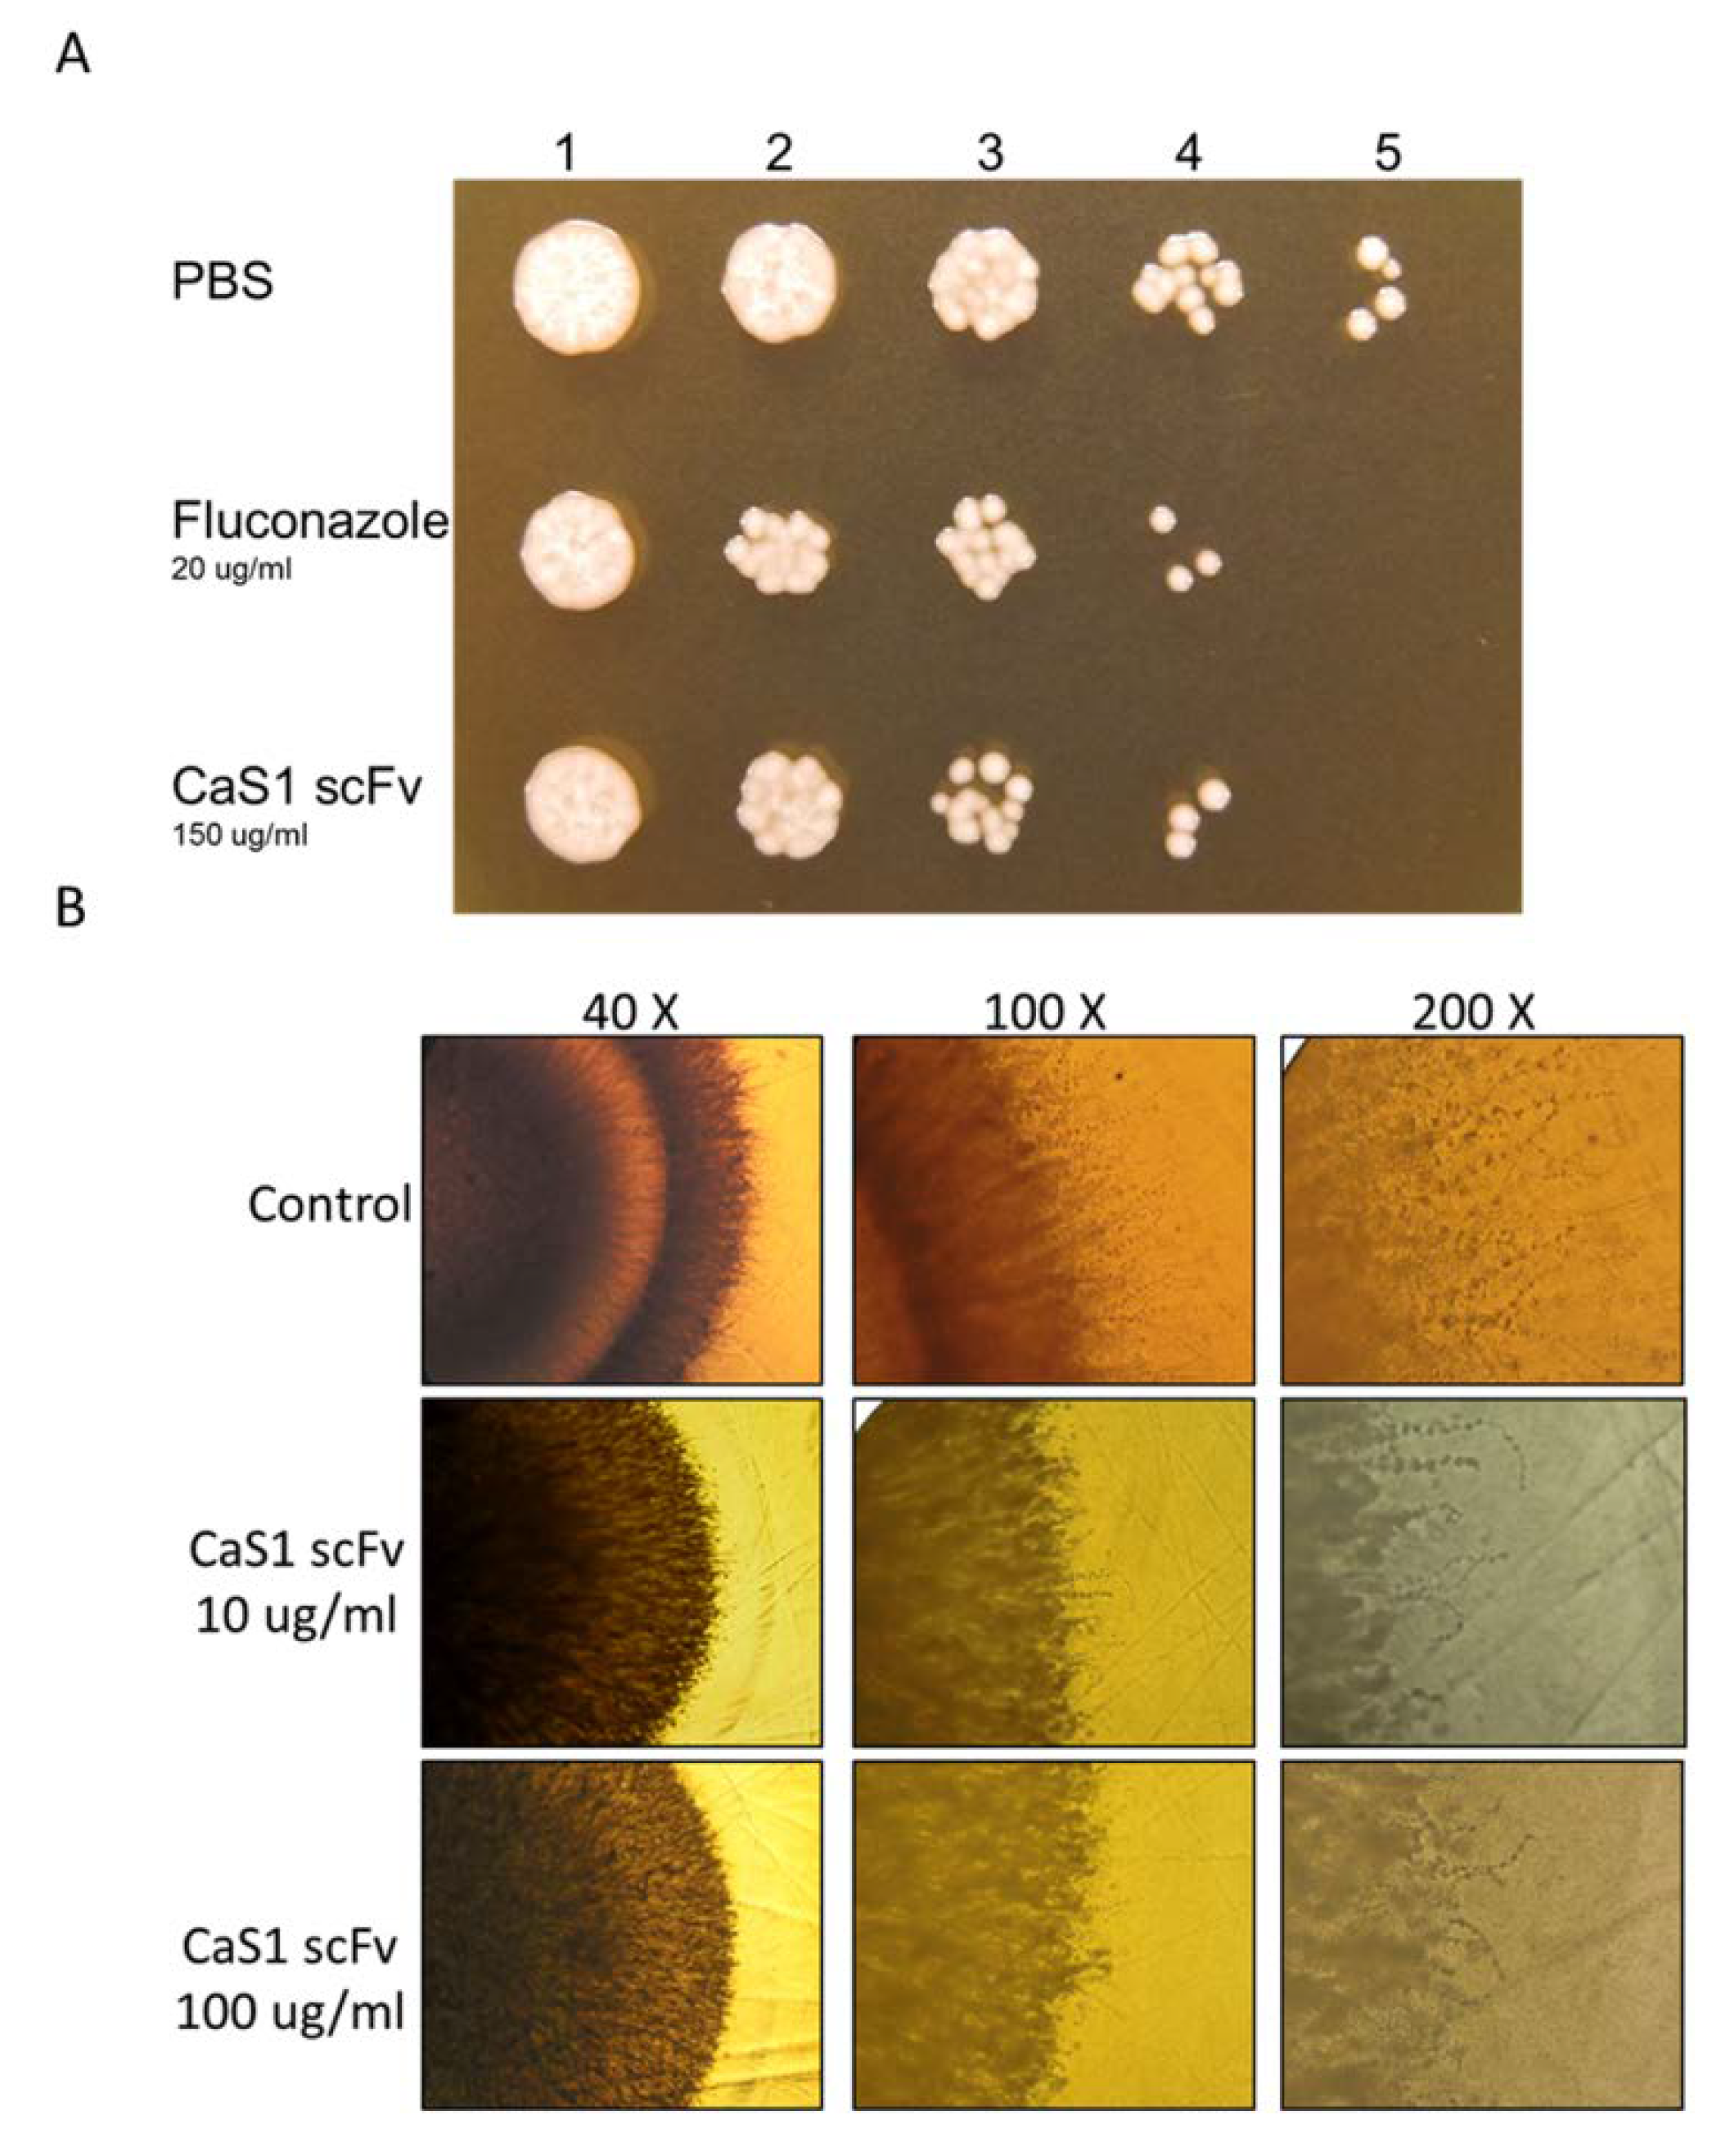
Ijms 21 02903 g002

Generation and Characterization of Single Chain Variable Fragment against Alpha-Enolase of Candida albicans
Abstract
1. Introduction
2. Results
2.1. Analysis of Anti-CaEno1 IgY Antibodies
2.2. Construction and Panning of Anti-CaEno1 Antibody Libraries
2.3. Binding Specificity of CaS1 scFv
2.4. Attenuation of C. albicans Growth by CaS1
2.5. Binding of CaS1 to Eno1 Proteins of Different Candida spp.
2.6. Inhibitory Binding of the CaEno1 of C. albicans to Plasminogen by CaS1
2.7. Effects of CaS1 on the Survival of Mice and Zebrafish Infected with C. albicans
2.8. CaS1 Reduced on Fungal Burden and Cytokine Levels on ICR Mice with Tail Vein Induced Candidiasis
3. Discussion
4. Materials and Methods
4.1. Expression and Purification of his-CaEno1 Protein
4.2. Animal Immunization
4.3. Construction and Biopanning of scFv Antibody Libraries
4.4. C. albicans Growth and Hyphal Formation
4.5. Western Blotting
4.6. Surface Plasmon Resonance (SPR)
4.7. Fibrin Matrix-Gel Degradation Analysis
4.8. Effect of CaS1 on C. albicans Infection in Mice
4.9. Effect of CaS1 on C. albicans Infection in Zebrafish Model
4.10. Zebrafish Egg Bath Infection
4.11. Statistical Analysis
4.12. Ethics Statement
Supplementary Materials
Author Contributions
Funding
Acknowledgments
Conflicts of Interest
Abbreviations
| Eno1 | alpha-enolase |
| CaEno1 | C. albicans alpha-enolase |
| SpEno1 | S. pneumoniae alpha-enolase |
| SaEno1 | S. aureus alpha-enolase |
| mEno1 | mice alpha-enolase |
| hEno1 | humans alpha-enolase |
| rCaEno1 | recombinant C. albicans alpha-enolase |
| scFv | single chain variable fragment |
| AmB | Amphotericin |
| DA | Deinagkistrodon acutus |
| NC | nitrocellulose |
| MDR | multidrug resistance |
| VH | heavy variable genes |
| VL | light variable genes |
| KD | dissociation constant value |
| FLUR | fluconazole-resistant |
| FLUS | fluconazole-susceptible |
| h | hour |
| s | second |
| min | minute |
References
- Tabah, A.; Koulenti, D.; Laupland, K.; Misset, B.; Valles, J.; Bruzzi de Carvalho, F.; Paiva, J.A.; Cakar, N.; Ma, X.; Eggimann, P.; et al. Characteristics and determinants of outcome of hospital-acquired bloodstream infections in intensive care units: The EUROBACT International Cohort Study. Intensive Care Med. 2012, 38, 1930–1945. [Google Scholar] [CrossRef] [PubMed]
- Paramythiotou, E.; Frantzeskaki, F.; Flevari, A.; Armaganidis, A.; Dimopoulos, G. Invasive fungal infections in the ICU: How to approach, how to treat. Molecules 2014, 19, 1085–1119. [Google Scholar] [CrossRef] [PubMed]
- Sievert, D.M.; Ricks, P.; Edwards, J.R.; Schneider, A.; Patel, J.; Srinivasan, A.; Kallen, A.; Limbago, B.; Fridkin, S. Antimicrobial-resistant pathogens associated with healthcare-associated infections: Summary of data reported to the National Healthcare Safety Network at the Centers for Disease Control and Prevention, 2009–2010. Infect. Control Hosp. Epidemiol. 2013, 34, 1–14. [Google Scholar] [CrossRef] [PubMed]
- Wisplinghoff, H.; Bischoff, T.; Tallent, S.M.; Seifert, H.; Wenzel, R.P.; Edmond, M.B. Nosocomial bloodstream infections in US hospitals: Analysis of 24,179 cases from a prospective nationwide surveillance study. Clin. Infect. Dis. 2004, 39, 309–317. [Google Scholar] [CrossRef]
- Berenguer, J.; Buck, M.; Witebsky, F.; Stock, F.; Pizzo, P.A.; Walsh, T.J. Lysis-centrifugation blood cultures in the detection of tissue-proven invasive candidiasis. Disseminated versus single-organ infection. Diagn. Microbiol. Infect. Dis. 1993, 17, 103–109. [Google Scholar] [CrossRef]
- Guinea, J. Global trends in the distribution of Candida species causing candidemia. Clin. Microbiol. Infect. 2014, 20 (Suppl. 6), 5–10. [Google Scholar] [CrossRef]
- Yapar, N. Epidemiology and risk factors for invasive candidiasis. Ther. Clin. Risk Manag. 2014, 10, 95–105. [Google Scholar] [CrossRef]
- Deray, G. Amphotericin B nephrotoxicity. J. Antimicrob. Chemother. 2002, 49 (Suppl. 1), 37–41. [Google Scholar] [CrossRef] [PubMed]
- Pfaller, M.A. Antifungal drug resistance: Mechanisms, epidemiology, and consequences for treatment. Am. J. Med. 2012, 125 (Suppl. 1), S3–S13. [Google Scholar] [CrossRef] [PubMed]
- Marchaim, D.; Lemanek, L.; Bheemreddy, S.; Kaye, K.S.; Sobel, J.D. Fluconazole-resistant Candida albicans vulvovaginitis. Obstet. Gynecol. 2012, 120, 1407–1414. [Google Scholar] [CrossRef] [PubMed]
- Danby, C.S.; Boikov, D.; Rautemaa-Richardson, R.; Sobel, J.D. Effect of pH on in vitro susceptibility of Candida glabrata and Candida albicans to 11 antifungal agents and implications for clinical use. Antimicrob. Agents Chemother. 2012, 56, 1403–1406. [Google Scholar] [CrossRef]
- Sekhavat, L.; Tabatabaii, A.; Tezerjani, F.Z. Oral fluconazole 150 mg single dose versus intra-vaginal clotrimazole treatment of acute vulvovaginal candidiasis. J. Infect. Public Health 2011, 4, 195–199. [Google Scholar] [CrossRef] [PubMed]
- Pinto, E.; Ribeiro, I.C.; Ferreira, N.J.; Fortes, C.E.; Fonseca, P.A.; Figueiral, M.H. Correlation between enzyme production, germ tube formation and susceptibility to fluconazole in Candida species isolated from patients with denture-related stomatitis and control individuals. J. Oral Pathol. Med. 2008, 37, 587–592. [Google Scholar] [CrossRef] [PubMed]
- Sirover, M.A. Emerging new functions of the glycolytic protein, glyceraldehyde-3-phosphate dehydrogenase, in mammalian cells. Life Sci. 1996, 58, 2271–2277. [Google Scholar] [CrossRef]
- Sirover, M.A. New insights into an old protein: The functional diversity of mammalian glyceraldehyde-3-phosphate dehydrogenase. Biochim. Biophys. Acta 1999, 1432, 159–184. [Google Scholar] [CrossRef]
- Plow, E.F.; Das, R. Enolase-1 as a plasminogen receptor. Blood 2009, 113, 5371–5372. [Google Scholar] [CrossRef]
- Jong, A.Y.; Chen, S.H.; Stins, M.F.; Kim, K.S.; Tuan, T.L.; Huang, S.H. Binding of Candida albicans enolase to plasmin(ogen) results in enhanced invasion of human brain microvascular endothelial cells. J. Med. Microbiol. 2003, 52 Pt 8, 615–622. [Google Scholar] [CrossRef] [PubMed]
- Diaz-Ramos, A.; Roig-Borrellas, A.; Garcia-Melero, A.; Lopez-Alemany, R. alpha-Enolase, a multifunctional protein: Its role on pathophysiological situations. J. Biomed. Biotechnol. 2012, 2012, 156795. [Google Scholar] [CrossRef] [PubMed]
- Pancholi, V. Multifunctional alpha-enolase: Its role in diseases. Cell. Mol. Life Sci. 2001, 58, 902–920. [Google Scholar] [CrossRef] [PubMed]
- Ko, H.C.; Hsiao, T.Y.; Chen, C.T.; Yang, Y.L. Candida albicans ENO1 null mutants exhibit altered drug susceptibility, hyphal formation, and virulence. J. Microbiol. 2013, 51, 345–351. [Google Scholar] [CrossRef]
- Yang, Y.L.; Chen, H.F.; Kuo, T.J.; Lin, C.Y. Mutations on CaENO1 in Candida albicans inhibit cell growth in the presence of glucose. J. Biomed. Sci. 2006, 13, 313–321. [Google Scholar] [CrossRef] [PubMed]
- Silva, R.C.; Padovan, A.C.; Pimenta, D.C.; Ferreira, R.C.; da Silva, C.V.; Briones, M.R. Extracellular enolase of Candida albicans is involved in colonization of mammalian intestinal epithelium. Front. Cell. Infect. Microbiol. 2014, 4, 66. [Google Scholar] [CrossRef] [PubMed]
- van Deventer, A.J.; van Vliet, H.J.; Hop, W.C.; Goessens, W.H. Diagnostic value of anti-Candida enolase antibodies. J. Clin. Microbiol. 1994, 32, 17–23. [Google Scholar] [CrossRef]
- Chen, Y.Z.; Yang, Y.L.; Chu, W.L.; You, M.S.; Lo, H.J. Zebrafish Egg Infection Model for Studying Candida albicans Adhesion Factors. PLoS ONE 2015, 10, e0143048. [Google Scholar] [CrossRef] [PubMed]
- Delaloye, J.; Calandra, T. Invasive candidiasis as a cause of sepsis in the critically ill patient. Virulence 2014, 5, 161–169. [Google Scholar] [CrossRef] [PubMed]
- Wright, W.F.; Overman, S.B.; Ribes, J.A. (1–3)-β-d-Glucan Assay: A Review of its Laboratory and Clinical Application. Lab. Med. 2011, 42, 679–685. [Google Scholar] [CrossRef]
- Bugli, F.; Cacaci, M.; Martini, C.; Torelli, R.; Posteraro, B.; Sanguinetti, M.; Paroni Sterbini, F. Human monoclonal antibody-based therapy in the treatment of invasive candidiasis. Clin. Dev. Immunol. 2013, 2013, 403121. [Google Scholar] [CrossRef] [PubMed]
- Hodgetts, S.; Nooney, L.; Al-Akeel, R.; Curry, A.; Awad, S.; Matthews, R.; Burnie, J. Efungumab and caspofungin: Pre-clinical data supporting synergy. J. Antimicrob. Chemother. 2008, 61, 1132–1139. [Google Scholar] [CrossRef]
- Ostrosky-Zeichner, L.; Casadevall, A.; Galgiani, J.N.; Odds, F.C.; Rex, J.H. An insight into the antifungal pipeline: Selected new molecules and beyond. Nat. Rev. Drug Discov. 2010, 9, 719–727. [Google Scholar] [CrossRef]
- Zhou, Z.L.; Lin, C.C.; Chu, W.L.; Yang, Y.L.; Lo, H.J.; Hospitals, T. The distribution and drug susceptibilities of clinical Candida species in TSARY 2014. Diagn. Microbiol. Infect. Dis. 2016, 86, 399–404. [Google Scholar] [CrossRef]
- Yang, Y.L.; Ho, Y.A.; Cheng, H.H.; Ho, M.; Lo, H.J. Susceptibilities of Candida species to amphotericin B and fluconazole: The emergence of fluconazole resistance in Candida tropicalis. Infect. Control Hosp. Epidemiol. 2004, 25, 60–64. [Google Scholar] [CrossRef] [PubMed]
- Ma, C.F.; Li, F.Q.; Shi, L.N.; Hu, Y.A.; Wang, Y.; Huang, M.; Kong, Q.Q. Surveillance study of species distribution, antifungal susceptibility and mortality of nosocomial candidemia in a tertiary care hospital in China. BMC Infect. Dis. 2013, 13, 337. [Google Scholar] [CrossRef] [PubMed]
- Yang, Z.T.; Wu, L.; Liu, X.Y.; Zhou, M.; Li, J.; Wu, J.Y.; Cai, Y.; Mao, E.Q.; Chen, E.Z.; Lortholary, O. Epidemiology, species distribution and outcome of nosocomial Candida spp. bloodstream infection in Shanghai. BMC Infect. Dis. 2014, 14, 241. [Google Scholar] [CrossRef] [PubMed]
- Lee, C.H.; Lee, Y.C.; Lee, Y.L.; Leu, S.J.; Lin, L.T.; Chen, C.C.; Chiang, J.R.; Mwale, P.F.; Tsai, B.Y.; Hung, C.S.; et al. Single Chain Antibody Fragment against Venom from the Snake Daboia russelii formosensis. Toxins 2017, 9, 347. [Google Scholar] [CrossRef] [PubMed]
- Akita, E.M.; Nakai, S. Comparison of four purification methods for the production of immunoglobulins from eggs laid by hens immunized with an enterotoxigenic E. coli strain. J. Immunol. Methods 1993, 160, 207–214. [Google Scholar] [CrossRef]
- Akita, E.M.; Nakai, S. Production and purification of Fab’ fragments from chicken egg yolk immunoglobulin Y (IgY). J. Immunol. Methods 1993, 162, 155–164. [Google Scholar] [CrossRef]
- Guiver, M.; Levi, K.; Oppenheim, B.A. Rapid identification of candida species by TaqMan PCR. J. Clin. Pathol. 2001, 54, 362–366. [Google Scholar] [CrossRef] [PubMed]
- Westerfield, M. The Zebrafish: A Guide for the Laboratory Use of Zebrafish (Brachydanio Reriro); Inst. of Neuroscience, University of Oregon: Eugene, OR, USA, 1993. [Google Scholar]
- Kimmel, C.B.; Ballard, W.W.; Kimmel, S.R.; Ullmann, B.; Schilling, T.F. Stages of embryonic development of the zebrafish. Dev. Dyn. 1995, 203, 253–310. [Google Scholar] [CrossRef]

| Library | Linker Length * | Library Size | Eluted Phage Titers after Each Round of Panning | |||
|---|---|---|---|---|---|---|
| 1st | 2nd | 3rd | 4th | |||
| CaEno1-S | 7 aa | 2.4 × 106 | 9.6 × 104 | 9.0 × 105 | 7.2 × 105 | 3.0 × 106 |
| CaEno1-L | 18 aa | 1.36 × 107 | 2.75 × 105 | 1.2 × 105 | 1.32 × 106 | 1.2 × 105 |
© 2020 by the authors. Licensee MDPI, Basel, Switzerland. This article is an open access article distributed under the terms and conditions of the Creative Commons Attribution (CC BY) license (http://creativecommons.org/licenses/by/4.0/).
Share and Cite
Leu, S.-J.; Lee, Y.-C.; Lee, C.-H.; Liao, P.-Y.; Chiang, C.-W.; Yang, C.-M.; Su, C.-H.; Ou, T.-Y.; Liu, K.-J.; Lo, H.-J.; et al. Generation and Characterization of Single Chain Variable Fragment against Alpha-Enolase of Candida albicans. Int. J. Mol. Sci. 2020, 21, 2903. https://doi.org/10.3390/ijms21082903
Leu S-J, Lee Y-C, Lee C-H, Liao P-Y, Chiang C-W, Yang C-M, Su C-H, Ou T-Y, Liu K-J, Lo H-J, et al. Generation and Characterization of Single Chain Variable Fragment against Alpha-Enolase of Candida albicans. International Journal of Molecular Sciences. 2020; 21(8):2903. https://doi.org/10.3390/ijms21082903
Chicago/Turabian StyleLeu, Sy-Jye, Yu-Ching Lee, Chi-Hsin Lee, Po-Yen Liao, Chen-Wei Chiang, Chieh-Ming Yang, Ching-Hua Su, Tsong-Yih Ou, Ko-Jiunn Liu, Hsiu-Jung Lo, and et al. 2020. "Generation and Characterization of Single Chain Variable Fragment against Alpha-Enolase of Candida albicans" International Journal of Molecular Sciences 21, no. 8: 2903. https://doi.org/10.3390/ijms21082903
APA StyleLeu, S.-J., Lee, Y.-C., Lee, C.-H., Liao, P.-Y., Chiang, C.-W., Yang, C.-M., Su, C.-H., Ou, T.-Y., Liu, K.-J., Lo, H.-J., Tsai, B.-Y., & Yang, Y.-Y. (2020). Generation and Characterization of Single Chain Variable Fragment against Alpha-Enolase of Candida albicans. International Journal of Molecular Sciences, 21(8), 2903. https://doi.org/10.3390/ijms21082903

